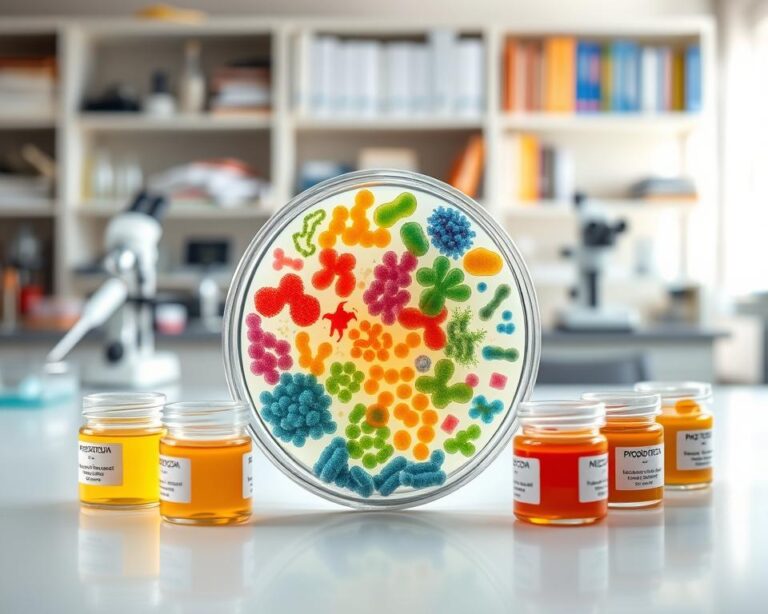
Live Bacteria Starters

Achieving Ecosystem Balance: My Top Tips

Did you know that a single species can significantly impact environmental equilibrium? Losing a key species can start a chain reaction, upsetting the whole ecosystem. I’m passionate about keeping our environment healthy, and I’ve learned how vital ecosystem balance is.…